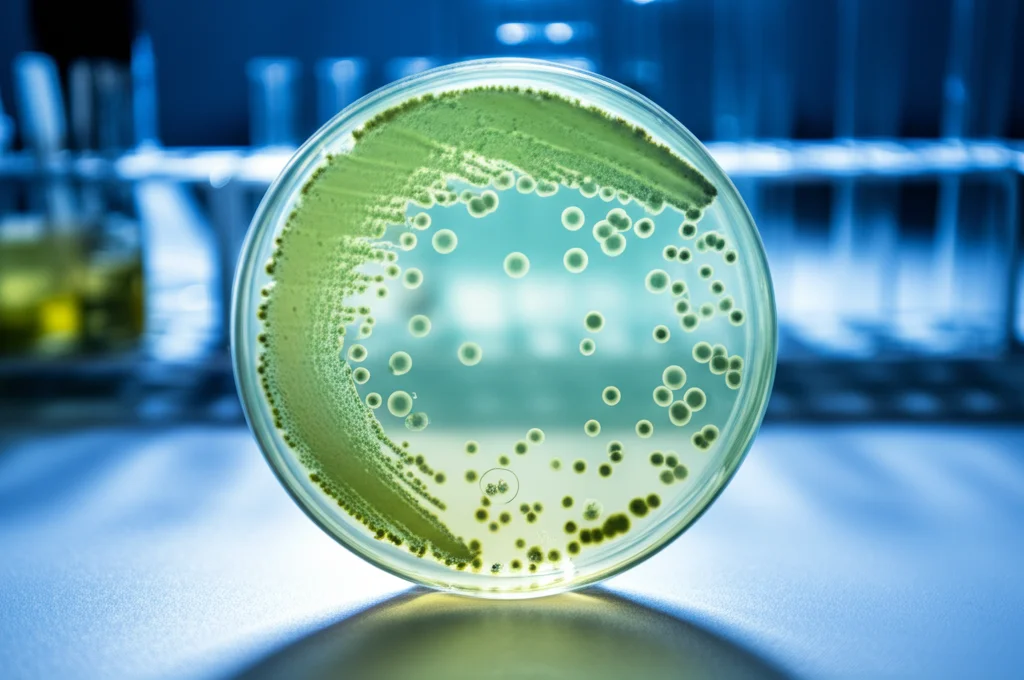
Natura morta, obiettivo macro 60mm, alta definizione, messa a fuoco precisa. Una capsula di Petri su un banco di laboratorio illuminato, contenente un terreno di coltura con colonie batteriche di Pseudomonas aeruginosa (verdastre). Si notano piccole aree circolari chiare (placche di lisi) dove i batteriofagi hanno ucciso i batteri. Alcune colonie crescono vicino alle placche, indicando possibile resistenza. Strumentazione di laboratorio (pipette, provette) sfocata sullo sfondo.

Fagi Terapeutici: Un Soffio di Speranza Contro le Infezioni Resistenti nella Fibrosi Cistica
Ciao a tutti! Oggi voglio parlarvi di qualcosa che mi appassiona tantissimo e che potrebbe davvero cambiare le carte in tavola nella lotta contro uno dei nemici più ostici della medicina moderna: la resistenza agli antibiotici. Immaginatevi un mondo dove le infezioni più comuni diventano incurabili. Fa paura, vero? Purtroppo, non è fantascienza. Entro il 2050, si stima che le morti causate da batteri resistenti potrebbero superare quelle per cancro. Un problema enorme, specialmente per chi convive con malattie croniche come la fibrosi cistica (FC).
La Sfida: Pseudomonas e la Fibrosi Cistica
Chi soffre di fibrosi cistica lo sa bene: le infezioni polmonari sono una compagna di viaggio frequente e pericolosa. E uno dei batteri più temuti è lo Pseudomonas aeruginosa. Questo microrganismo è un vero osso duro, capace di diventare resistente a quasi tutti gli antibiotici disponibili (MDR, multidrug-resistant) o addirittura a tutti (PDR, pan-drug-resistant). Per queste persone, le opzioni terapeutiche si riducono drasticamente, e le infezioni diventano sempre più difficili da gestire, peggiorando la qualità e l’aspettativa di vita. È una battaglia continua, spesso frustrante, sia per i pazienti che per i medici.
L’Idea Geniale: Fagi “Intelligenti” e il Compromesso Evolutivo
Ma se vi dicessi che la soluzione potrebbe arrivare da nemici naturali dei batteri stessi? Sto parlando dei batteriofagi, o più semplicemente “fagi”. Sono virus, ma tranquilli, attaccano solo ed esclusivamente i batteri, sono innocui per noi. Pensateli come dei cecchini super-specifici. L’idea di usarli come terapia (fagoterapia) non è nuova, ma sta tornando prepotentemente alla ribalta proprio per l’emergenza antibiotico-resistenza.
La vera “figata” di cui vi parlo oggi, però, è un approccio ancora più sofisticato: la terapia fagica personalizzata basata sul “trade-off” evolutivo. Cosa significa? In pratica, non si scelgono fagi a caso, ma si selezionano quelli che, oltre a uccidere il batterio target, lo costringono a un compromesso. Per sviluppare resistenza al fago, il batterio deve modificare qualcosa sulla sua superficie (ad esempio, le pompe che espellono gli antibiotici, il lipopolisaccaride (LPS) o i pili di tipo IV (TIVP), che sono come dei “tentacoli” usati per muoversi e aderire). Queste modifiche, però, possono renderlo meno cattivo: magari ridiventando sensibile agli antibiotici che prima ignorava, o perdendo parte della sua capacità di causare danno (virulenza). È come se, per schivare un proiettile (il fago), il batterio dovesse togliersi l’armatura (la resistenza o la virulenza). Geniale, no?

L’Esperienza: Nove Pazienti, Una Speranza Concreta
Recentemente, un gruppo di ricercatori ha messo in pratica questa strategia su nove pazienti adulti con fibrosi cistica (età tra 22 e 46 anni). Questi pazienti avevano infezioni polmonari da Pseudomonas aeruginosa MDR o PDR che non rispondevano più alle terapie antibiotiche standard. Si trattava di casi “compassionevoli”, cioè situazioni in cui si tenta una terapia sperimentale perché non ci sono altre opzioni valide.
La terapia è stata super personalizzata: per ogni paziente, sono stati selezionati i fagi più efficaci contro il suo specifico ceppo di Pseudomonas, isolato dall’espettorato. I fagi (a volte un singolo tipo, a volte un cocktail di 2 o 3) sono stati somministrati tramite nebulizzazione, direttamente nei polmoni, per 7-10 giorni. La cosa fantastica è che la terapia è stata ben tollerata: nessun evento avverso grave. Solo alcuni pazienti (quelli trattati a casa) hanno riportato un po’ di febbriciattola o stanchezza i primi giorni, cose lievi che non hanno richiesto trattamenti aggiuntivi.
I Risultati: Meno Batteri, Più Respiro
E i risultati? Davvero incoraggianti! Analizzando l’espettorato prima e dopo la terapia, si è vista una riduzione drastica della carica batterica di Pseudomonas. Parliamo di una diminuzione mediana di 10.000 volte (104 CFU/ml) poco dopo la fine del trattamento! E questa riduzione si manteneva significativa anche a distanza di qualche settimana. Meno batteri cattivi nei polmoni, è già una gran bella notizia.
Ma la cosa forse più importante per un paziente con FC è la funzione polmonare. Ebbene, anche qui i risultati sono stati positivi. Misurando la FEV1 (un parametro chiave della spirometria che indica quanto volume d’aria si riesce a espirare forzatamente in un secondo), si è osservato un miglioramento medio dell’8% (mediana 6%) tra 21 e 35 giorni dopo la terapia. Può sembrare poco, ma per chi lotta per ogni respiro, un miglioramento del genere può fare una differenza enorme nella vita quotidiana. Questo suggerisce che la combinazione della riduzione batterica e degli effetti “trade-off” dei fagi abbia avuto un impatto clinico tangibile.

Il “Prezzo” per i Batteri: Resistere ai Fagi Costa Caro
Ma torniamo al concetto di “trade-off”. Ha funzionato? Sembra proprio di sì. Analizzando i batteri sopravvissuti alla terapia, i ricercatori hanno trovato proprio quello che si aspettavano:
- I batteri erano diventati resistenti ai fagi utilizzati (segno che la terapia aveva esercitato una pressione selettiva).
- Nei due pazienti trattati con il fago OMKO1 (che mira alle pompe di efflusso), i batteri post-terapia erano diventati più sensibili a diversi antibiotici! Questo è importantissimo, perché riapre la porta a farmaci che prima erano inutili.
- Nei pazienti trattati con il fago TIVP-H6 (che attacca i pili), i batteri post-terapia mostravano una ridotta produzione di piocianina (una tossina che causa infiammazione) e una minore capacità di aderire alle cellule delle vie aeree. Meno adesione significa meno capacità di colonizzare e fare danno.
- Per il fago LPS-5 (che lega l’LPS), i risultati sulla virulenza sono stati un po’ più misti, ma si è vista una riduzione significativa della produzione di elastasi (un altro fattore di virulenza) in alcuni ceppi post-terapia.
Anche le analisi genetiche dei batteri prima e dopo la terapia hanno confermato la presenza di mutazioni nei geni legati ai recettori dei fagi (pompe, LPS, pili), supportando l’idea che la resistenza ai fagi sia avvenuta proprio come previsto, spesso a scapito di altre funzioni.
E il Resto del Microbioma?
Una preoccupazione con le terapie antimicrobiche è che possano “disturbare” l’equilibrio degli altri batteri presenti nei polmoni (il microbioma polmonare). Gli antibiotici, ad esempio, spesso fanno piazza pulita, colpendo anche i batteri “buoni”. In questo studio, invece, le analisi metagenomiche (che guardano a tutto il DNA batterico presente nell’espettorato) hanno mostrato che la terapia fagica non ha alterato significativamente la composizione generale della comunità batterica. I fagi sono stati molto specifici per lo Pseudomonas, senza creare squilibri importanti. Un altro punto a favore!
Certo, Non è Tutto Oro Ciò Che Luccica
Ok, sembra tutto bellissimo, ma dobbiamo essere onesti. Questo è uno studio su un piccolo numero di pazienti (solo nove) e senza un gruppo di controllo (cioè pazienti simili non trattati con i fagi, per confronto). Era uno studio compassionevole, quindi c’erano differenze tra i pazienti (genetica, gravità della malattia, altre terapie in corso) e anche nei protocolli di trattamento (fagi diversi, durata, frequenza, tipo di nebulizzatore). Inoltre, si sono analizzati solo alcuni ceppi batterici per paziente, e la popolazione batterica nei polmoni con FC è spesso molto eterogenea.
Quindi, calma e gesso. Questi risultati sono estremamente promettenti e mostrano che la fagoterapia personalizzata inalatoria è sicura e potenzialmente efficace, con benefici sia microbiologici che clinici. Ma servono assolutamente studi clinici più ampi e controllati per confermare questi dati e capire meglio come ottimizzare questa strategia. Ci sono già trial clinici in corso (come CYPHY a Yale, e altri promossi da aziende farmaceutiche), e speriamo che presto ci diano risposte più definitive.
In conclusione, la fagoterapia personalizzata, soprattutto con questo approccio “intelligente” basato sui trade-off, rappresenta davvero un fascio di luce nella difficile battaglia contro le infezioni resistenti nella fibrosi cistica e, potenzialmente, in molte altre condizioni. È un esempio affascinante di come possiamo imparare dalla natura per sviluppare nuove armi terapeutiche. Teniamo le dita incrociate!
Fonte: Nature Medicine (Nota: il link fornito nell’abstract originale puntava a un articolo con DOI finale diverso, s41591-025-03678-8, che potrebbe essere una versione successiva o correlata. Ho usato il link fornito nella richiesta originale per coerenza, ma il DOI nel testo abstract è s41591-024-02945-y).







